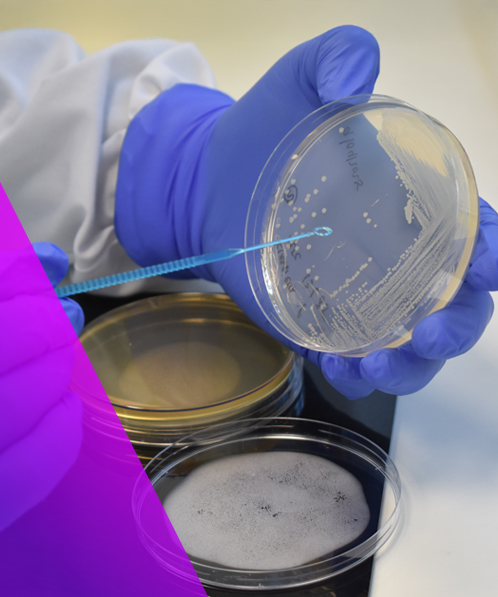

Biocides
Comprehensive testing to assess efficacy of biocides
What Are Biocides?
Biocides are chemical products used to control harmful organisms, for example bacteria, fungi and viruses. Biocides can be disinfectants, preservatives, antimicrobial wipes, antimicrobial surfaces, handwashes and handrubs.

Testing Biocides
Biocidal products on the market must comply with strict regulations. Within the European Union, the placement of biocides on the market is regulated by the Biocidal Products Regulation (BPR) overseen by the European Chemicals Agency (ECHA). In the UK, the Health & Safety Executive (HSE) regulates biocides under GB BPR and other areas will each have their own regulations. These guidelines aim to ensure the activity of biocides on the market while also protecting users and the environment.
Types of tests
Biocidal testing is often broken down into suspension tests, where liquids are challenged with the target organism, and carrier tests, where the selected organism is dried onto a surface which is then treated with the product. Standard test methods will specify which organisms should be tested, contact times and testing temperatures. All of these are designed to mimic the environment in which the product will be used. They may also specify the use of an interfering substance, such as protein or blood, which presents an increased challenge.
Why Virologica
Providing Quality, Expert Testing Services

Knowledge
Our scientists are experienced in a range of biocidal methods against viruses, bacteria and fungi.

Quality
We understand how important each test is to you and our team is committed to delivering high-quality data.

Flexible
We can work with you to adapt methods if your product does not exactly fit the standard.

Communication
We provide realistic timelines from the outset and keep you in the loop if anything changes.

Selection of Relevant Standards
EN 14476
Quantitative suspension test for the evaluation of virucidal activity of chemical disinfectants used in the medical area (phase 2, step 1)
EN 1276
Quantitative suspension test for the evaluation of bactericidal activity of chemical disinfectants and antiseptics used in food, industrial, domestic and institutional areas (phase 2, step 1)
Minimum Inhibitory Concentration (MIC)
Test to determine the lowest concentration of a biocide needed to prevent bacterial growth.
What Our Customers Say…
“Customers needed to know that harmful viruses could be completely removed from our medical device prior to reuse. Virologica’s rigorous experimental protocol quickly delivered the clear and reliable evidence we needed.”
Technical Manager, Healthcare Business
Start The Conversation
Contact us today to explore how we can support you with your next project.